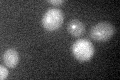
YER185W
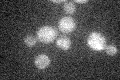
YER185W

View description
Plasma membrane protein with roles in the uptake of protoprophyrin IX and the efflux of heme; expression is induced under both low-heme and low-oxygen conditions; member of the fungal lipid-translocating exporter (LTE) family of proteins
Localization:
Intensity:
Fold change:
Significance:
-
C’ GFP library in SD

below threshold15.63 -
N' NOP1pr-GFP in SD

ER50.7593 -
N' TEF2pr-mCherry in SD

cell periphery,punctate,vacuole65.53 -
N' NATIVEpr-GFP in SD

below threshold18.5544 -
N' TEF2pr-VC and Cyto-VN in SD

below threshold22.128 -
C’ GFP library in SD+DTT
cytosol16.731.07No -
C’ GFP library in SD+H2O2
cytosol15.080.96No -
C’ GFP library in Starvation Media

cytosol22.121.41No -
C’ GFP library on the background of Pup2-DaMP

below threshold -
C’ GFP library on the background of CCT mutant

below threshold17.10771.09436No
